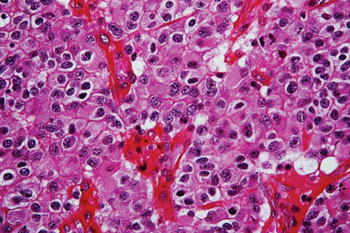
图片：少突胶质细胞瘤的组织病理图，根据高度的细胞病变做出诊断，病变细胞就像煎蛋，细胞边界清晰，有中度到明显的核异型（图片蒙Nephron公司惠赐）。

准确测定脑肿瘤基因图谱的快速检验
By LabMedica International staff writers
Posted on 27 Apr 2016
用新近开发的下一代基因测序检验产品能迅速准确地测定脑肿瘤的特征谱。该检验名为GlioSeq,肿瘤医师现在正用它辅助引导脑癌的治疗规划。Posted on 27 Apr 2016
以前诊断中央神经系统(CNS)肿瘤一直主要基于组织病理特征。然而,肿瘤形态相同的病人也许出现不同的临床结果和治疗效果,因为肿瘤的深层基因特征不同。
图片:少突胶质细胞瘤的组织病理图,根据高度的细胞病变做出诊断,病变细胞就像煎蛋,细胞边界清晰,有中度到明显的核异型(图片蒙Nephron公司惠赐)。
美国宾夕法尼亚州匹兹堡大学健康科学学院(PA, USA)的科学家及其同事用下一代基因测序分析——GlioSeq检验54份成人和儿童脑肿瘤样本中的基因异常,包括点突变、基因融合和小基因插入和删除,这些异常已经过其它方式鉴定。他们用下一代测序同时鉴定这些肿瘤所有以前已知的变异以及另外的许多基因标记物。这提供了有关肿瘤分类以及可能的新治疗靶体的重要信息。
科研小组发现了CNS肿瘤里常见的30条变异基因,并定制了DNA引物池,以生成文库和序列。用2012–2015年间收集的54份CNS肿瘤样本评估GlioSeq性能,其中包括28份福尔马林固定石蜡包埋(FFPE)组织和26份速冻组织。所测试的54份样本DNA文库制备和测序全部成功。研究人员比较了GlioSeq的试剂成本与Sanger测序、逆转录聚合酶链反应(RT-PCR)和单核苷酸多态性阵列等传统技术的试剂成本,认定传统方法的成本是GlioSeq分析的15倍。
该研究的论文发表于2015年12月17日的《Neuro-Oncology》杂志。论文合著者之一、神经内科、神经外科暨肿瘤医学教授Frank S. Lieberman大夫说:“这项检验能辅助引导医师和病人进行治疗规划,因为分子信息让我们能更精确地鉴定肿瘤,更有把握地预测生存率和治疗效果。此外,Glioseq有利于确定临床实验该选用哪些合适的分子靶体以及发现存在分子靶向药的病例。”
Related Links:
匹兹堡大学健康科学学院








